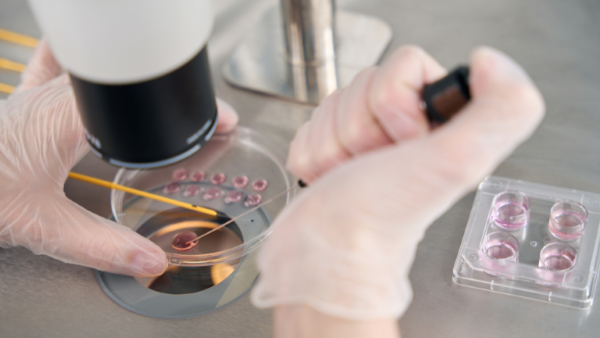

A “adoção” de embriões é uma possibilidade real para pessoas que sonham em gestar um bebê, mas não podem recorrer a embriões próprios. A prática ocorre quando casais que passaram por tratamentos de fertilização in vitro (FIV) compartilham embriões excedentes que foram criopreservados e não pretendem mais utilizar.
“A doação de embriões é uma alternativa ética e segura para casais que desejam gestar, mas enfrentam dificuldades, seja por idade avançada, falhas repetidas em tratamentos ou ausência de gametas viáveis. Ao mesmo tempo, permite que embriões congelados não permaneçam indefinidamente armazenados sem destino”, explica o ginecologista especialista em reprodução humana Dr. Vamberto Maia Filho.
Segundo dados da Agência Nacional de Vigilância Sanitária (Anvisa), mais de 85 mil embriões estão atualmente congelados no Brasil e muitos deles permanecem sem destino definido após o fim do tratamento dos casais. A resolução mais recente do Conselho Federal de Medicina (CFM), a Resolução CFM nº 2.294/21, permite que esses embriões sejam doados de forma voluntária e anônima a outros pacientes inférteis.
Quem pode doar e quem pode receber?
De acordo com o CFM, podem doar embriões os casais que concluíram seu projeto reprodutivo e não pretendem mais utilizar os embriões congelados. A decisão deve ser documentada e o consentimento informado, atualizado e assinado por ambas as partes.
Por outro lado, podem receber embriões os pacientes com infertilidade comprovada, casais homoafetivos ou mulheres que optem por uma produção independente, mediante avaliação médica. O procedimento exige que a clínica de reprodução humana respeite os critérios técnicos e éticos estabelecidos, incluindo o sigilo da identidade dos doadores.
“Diferentemente da adoção jurídica de uma criança, a doação de embriões é tratada como um ato médico, sigiloso e sem vínculo legal entre as partes. Quem recebe o embrião será, perante a lei, a mãe ou os pais da criança nascida”, reforça o Dr. Vamberto.
Implicações legais e éticas
A legislação brasileira proíbe a comercialização de gametas e embriões. Toda doação deve ser voluntária e sem fins lucrativos. Além disso, não há exigência de semelhança fenotípica (aparência física) entre doadores e receptores, mas as clínicas costumam levar em consideração critérios de compatibilidade, como tipo sanguíneo e características físicas básicas.
Por se tratar de um tema delicado, muitos pacientes ainda têm dúvidas ou resistência em relação à doação de embriões. No entanto, esse caminho tem ganhado relevância diante do aumento da demanda por alternativas reprodutivas inclusivas.
“É uma decisão que exige maturidade emocional e acompanhamento médico e psicológico. Mas também representa uma possibilidade linda de tornar a gestação viável para quem achava que não poderia passar por essa experiência”, finaliza o especialista.
Burocracias que dificultam a doação
Apesar de ser uma alternativa importante para ampliar o acesso à gestação, o processo de doação de embriões enfrenta hoje entraves práticos que podem desestimular os casais doadores. Isso porque, segundo a regulamentação atual da Anvisa, a doação de embriões requer que o casal realize uma série de exames laboratoriais, os mesmos exigidos para a doação de óvulos ou sêmen, como sorologias para HIV, hepatites, HTLV, Zika vírus, clamídia, gonorreia, além de cariótipo, eletroforese de hemoglobina e dosagem de hormônio AMH. Esses testes, no entanto, não são obrigatórios durante um ciclo convencional de fertilização in vitro (FIV).
Na prática, isso significa que, mesmo após realizarem o tratamento e congelarem embriões excedentes, os casais que desejam doar precisam retornar posteriormente para complementar os exames exigidos, etapa que muitos acabam não concluindo.
“Infelizmente, a maioria dos casais não volta para fazer esses exames adicionais. É um paradoxo: os testes não são obrigatórios para gerar os embriões, mas se tornam obrigatórios para doá-los. Isso dificulta muito a efetivação da doação”, explica o Dr. Vamberto Maia Filho. “Precisamos revisar esse modelo se quisermos tornar a doação de embriões uma prática mais acessível e efetiva no Brasil.”
Publicado por Guia do Bebê